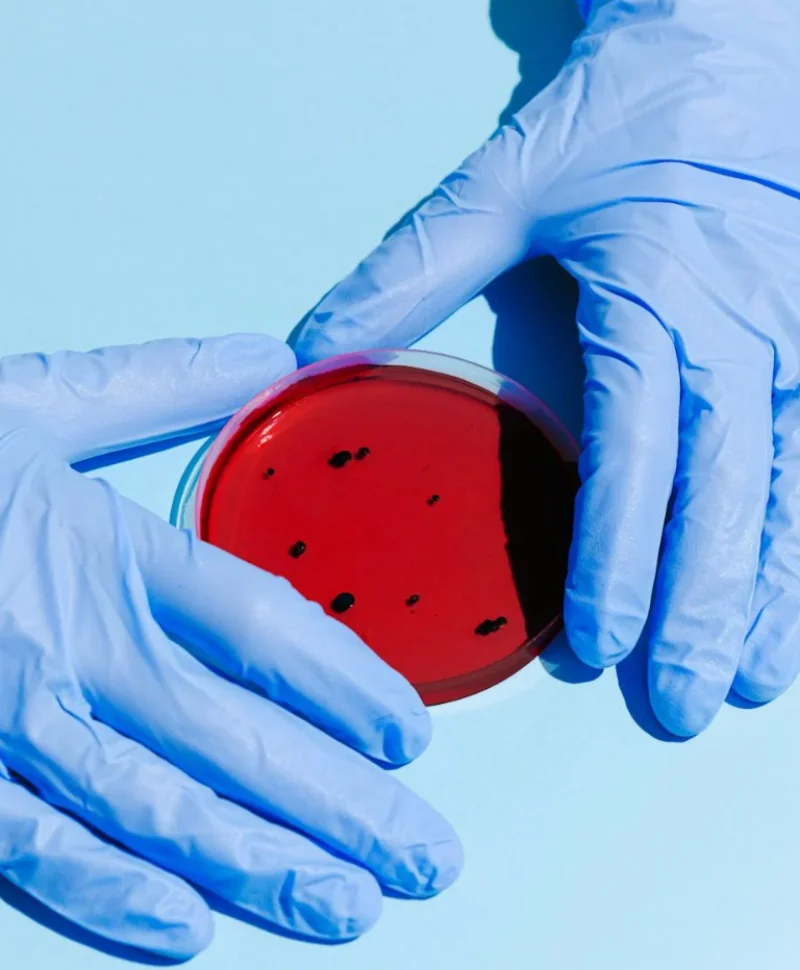
연쇄구균독성쇼크증후군
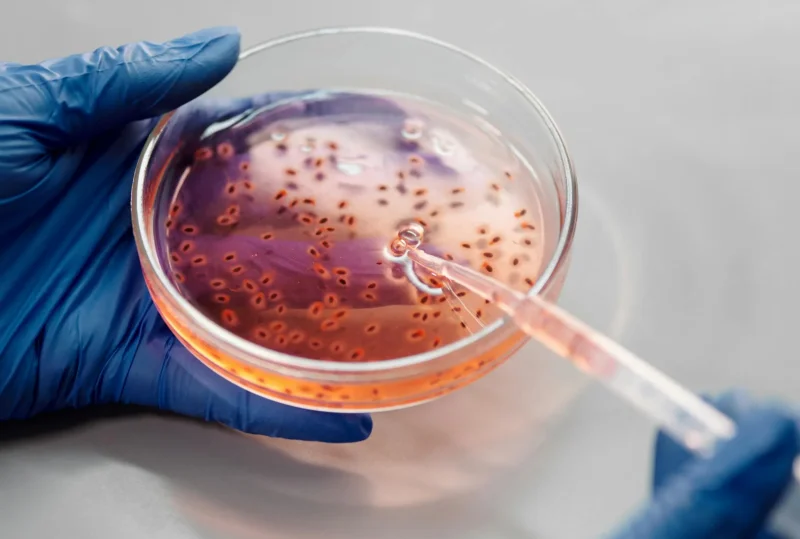
연쇄구균 독성쇼크증후군 증상

최근 일본에서 연쇄상구균 독성쇼크증후군(STSS)이 급속히 확산되고 있습니다. 치사율 30%로 전해지는 일본 감염병 STSS증상과 예방법에 대해 정리했습니다. 일본 여행을 계획하는 한국인 관광객들은 연쇄구균 독성쇼크증후군 정보 및 예방법을 숙지하시기 바랍니다.
지리적으로 가까운 우리나라는 일본 감염병 출현으로 전염될 우려가 커지고 있습니다. 현재 STSS증상에 관한 특징과 주의사항에 대해 살펴보겠습니다.
일본 감염병
현재 일본 감염병으로 알려진 A군 연쇄상구균이 확산되고 있습니다. A형 연쇄구균 박테리아에 의해 발생하는 STSS는 심장질환, 관절염 등의 합병증을 일으킬 수 있고 중증 진행 시 치사율 30$라고 전해지고 있습니다.
2024년 3월 기준 일본에서는 47개 중 45개 현에서 STSS감염이 확인 되었습니다. 거의 모든 현에서 A군 연쇄상구균 감염환자가 발생하고 있으며 474명의 STSS증상 사례가 보고되었습니다.

지난해 STSS증상 환자가 941명인 것과 비교하면 절반이상의 감염자가 나왔으며 올해 감염 속도는 매우 빠른 것으로 전해집니다.
일본 국립감염병연구소(NIID)의 노력에도 불구하고 이러한 급속한 확산의 원인은 아직 밝혀지지 않았습니다. 보통 감염병은 고령자 노인에의 치사율이 높지만 A군 연쇄상구균 사망자의 대부분은 50세 미만인 것으로 보고 되고 있습니다.
연쇄구균 독성쇼크증후군(STSS)
STSS 증상
연쇄구균 독성쇼크증후군(STSS)는 고열, 설사, 구토, 근육통, 피부 발진 등의 증상으로 나타납니다. 초기 증상은 일반적인 감기 증상과 유사하여 감지가 어려울 수 있습니다. 초기 무증상으로 진행되는 경우도 빈번한 것으로 알려졌습니다.
STSS증상 특징
- 무증상
- 38도 고열
- 인두염
증상은 바로 나타나지 않고 무증상으로 진행되다가 38도 이상의 고열과 인두염을 동반합니다. 이와 비슷한 증상이 나타나면 즉각적인 치료가 중요합니다.
STSS 합병증

연쇄구균 독성쇼크증후군은 면역 반응을 일으켜 심각한 합병증으로 이어집니다. 연쇄상구균을 공격해야하는 면역체가 심장 조직을 공격하여 심장 판막증을 발생시키며 관절을 공격하면서 관절염 등의 증상을 발생시킵니다.
중중인 경우 신체조직을 괴사 시키고 장기기능을 급속도로 떨어뜨리는 다발성 장기부전 증상이 발생합니다. 연쇄구균 독성쇼크증후군을 일으키는 연쇄상구균은 일명 '식인 박테리아'러 불리기도 합니다.
STSS 치사율
STSS 치사율은 최대 30%에 달할 수 있으며, 특히 30세 이상의 성인에게 심각한 위협이 됩니다. 고령자보다는 젊은층의 중증진행 사례가 많기 때문에 주의를 당부하고 있습니다.
STSS 확산 속도
STSS는 일본에서 놀라운 속도로 확산되고 있으며, 2023년에는 사례가 이전 수준을 넘어설 것으로 예상됩니다. NIID는 지난해 941건을 보고했으며, 2024년 첫 두 달 동안만 378건이 등록되었습니다. 급속한 사례 증가는 상황의 심각성을 강조합니다.



전문가들은 연쇄구균 독성쇼크증후군 확산 원인을 두고 코로나 팬데믹 시기 대규모 방역 조치로 인해 감염병 유행이 억제되면서 집단 면역력을 갖추지 못했기 때문이라고 전하기도 합니다.
집단면역이 형성되지 않은 상태에서 자가격리 의무가 사라지자 손씻기 등과 같은 기본 방역수칙이 느슨해진 원인도 덧붙였습니다.
STSS 감염 경로
연쇄구균 독성쇼크증후군은 전염력이 매우 높습니다. A군 연쇄상구균은 감염 환자의 타액과 분비물을 통해 전염됩니다.
특히 손이나 발의 상처를 통해서도 환자에게 감염될 수 있다. 항생제로 감염을 치료할 수 있지만 심각한 경우에는 집중 치료가 필요할 수 있습니다.
STSS 예방법



아직 국내에는 일본 감염병 전염 소식이 전해진 바 없습니다. STSS 전염병이 확산되는 상황에서 특히 일본 여행 시 철저한 위생을 유지하는 것이 무엇보다 중요합니다.
여행자 STSS예방법
- 철저한 손씻기
- 마스크 착용
- 기침예절 실천
일본 여행자는 보건복지부나 세계보건기구(WHO) 등 보건 당국의 공식 지침을 준수해야 합니다. 철저한 손씻기를 포함한 기본적인 개인위생수칙은 필수입니다.

특히 가까운 시일 내에 일본을 여행할 계획이라면 정기적인 건강 검진과 필수 예방접종을 권장합니다.
결론적으로, 일본을 여행하는 여행자에게는 STSS에 대한 인식과 예방 조치 준수가 중요합니다.
STSS 검사
일본 여행 후 STSS증상이 의심된다면 검역관리소에서 증상확인을 하실 수 있습니다.
국내 국립검역소는 전국 13개을 운영하고 있습니다. 인천공항검역소, 부산검역소, 인천검역소, 평택검역소, 군산검역소, 울산검역소, 포항검역소, 동해검역소, 목포검역소, 국립여수검역소, 마산검역소, 김해공항검역소, 제주검역소 13개 입니다.
해외 방문 후 의심증상이 조금이라도 있다면 국립검역소를 통해 건강상태를 확인해 보시기 바랍니다.
여행자는 일본 감염병 정보를 얻고 필요한 예방 조치를 취함으로써 STSS에 감염될 위험을 완화하고 안전하고 즐거운 여행을 보장할 수 있습니다.
특히 전염병이 확산되고 있는 상황에서 여행 시 건강관리를 최우선으로 생각하시기 바랍니다. 안전을 유지하고 STSS 정보를 숙지하여 책임감 있는 여행하시기 바랍니다.

함께 보면 좋은글
'건강' 카테고리의 다른 글
| 라임병 증상 감염원인 및 예방법 치료 알아두세요 (1) | 2024.03.27 |
|---|---|
| 우롱차 효능 철관음 대홍포 동방미인 동정오룡 종류 특징은? (0) | 2024.03.18 |
| 곱창김 효능 굽기 방법 곱창김 뜻은? (0) | 2024.03.08 |